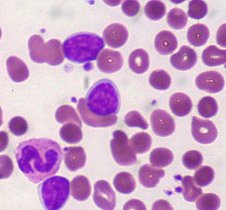

Artigo publicado no Lancet Oncology (Vol. 16 Number 1 | Jan 2015), assinado por Xavier Thomas, do Lyon-Sud Hospital, analisou a eficácia do blinatumomabe no tratamento de adultos com leucemia linfoblástica aguda.
Artigo publicado no Lancet Oncology (Vol. 16 Number 1 | Jan 2015), assinado por Xavier Thomas, do Lyon-Sud Hospital, analisou a eficácia do blinatumomabe no tratamento de adultos com leucemia linfoblástica aguda.
A quimioterapia padrão de leucemia linfoblástica aguda (LLA) está longe de ser ideal. Embora o uso de agentes citotóxicos tenha melhorado o prognóstico das crianças com LLA, esta abordagem tem apresentado poucos benefícios em adultos. A maioria dos pacientes respondem à quimioterapia de indução, mas até 50% experimentam recidivas com doença quimiorresistente. Persistência ou reaparecimento da doença residual mínima (DRM) é o mais importante fator prognóstico adverso. Regimes de quimioterapia não apresentam bons resultados na doença recidivada ou refratária e esse subgrupo de pacientes permanece com a necessidade de novas terapias.
Blinatumomabe pertence a uma nova classe de anticorpos monoclonais construídos para atuar junto aos linfócitos T e exercer ação seletiva, direcionando o sistema imunológico humano a agir contra as células tumorais, em especial no antígeno CD19, associado a LLA.
Max Topp e colegas conduziram um estudo de fase II com 189 pacientes tratados com blinatumomabe e descreveram uma atividade clínica com altas taxas de resposta DRM, mesmo em pacientes intensamente pré-tratados. Após dois ciclos, 81 pacientes (43%, 95% CI 36-50) atingiram o objetivo primário de resposta completa ou resposta completa hematológica. Os eventos adversos mais importantes foram toxicidades neurológicas reversíveis e aplasia.
Análise
Apesar destes resultados encorajadores, algumas questões devem ser mencionadas. Em primeiro lugar, ainda é preciso definir quais pacientes irão se beneficiar do tratamento com blinatumomabe. O risco de reações graves pode resultar na liberação maciça de citocinas, como relatado com outros anticorpos monoclonais. O blinatumomabe também provoca a deleção de células B, levando a quedas em níveis de imunoglobulina e aumentando o risco de infecções. A droga possui uma meia-vida relativamente curta, fazendo com que a infusão contínua ao longo de ciclos de quatro semanas através de uma mini-bomba portátil seja o melhor modo de administração, o que pode ser um desafio em pacientes debilitados.
Em segundo lugar, permanecem dúvidas sobre a melhor forma de usar o blinatumomabe: como um agente único ou em terapia de combinação, por indução, consolidação, ou manutenção, ou como parte de uma grande combinação ou sucessão de tratamentos? A incorporação de blinatumomabe na quimioterapia convencional, potencialmente incluindo outros anticorpos monoclonais, deve produzir oportunidades para avaliar a viabilidade de tais combinações e aumentar a eficácia do tratamento.
Análises iniciais sugerem que parece mais provável o uso de blinatumomabe de modo sequencial com quimioterapia, em vez de simultaneamente. Também parece haver papel para o uso de blinatumomabe em recidivas moleculares após transplante, para ampliar o efeito de infusões de linfócitos do doador. Além disso, o transplante alogênico continua a ser o principal objetivo da terapia em LLA de alto risco. Um ponto emergente é a viabilidade do transplante após o tratamento com blinatumomabe.
Vários fatores devem ser considerados para esta abordagem, incluindo a probabilidade de atingir a remissão, efeitos tóxicos e o tempo necessário para o rastreamento, inscrição e tratamento dos pacientes antes do transplante. Finalmente, novas estratégias terapêuticas podem se concentrar em alvos que exploram a renovação e diferenciação de células-tronco. Uma questão importante a favor da terapia de combinação é que blinatumomabe pode ter como alvo células de leucemia em massa, mas não células estaminais de leucemia, suposição apoiada pela curta duração do seu efeito.
Referências: http://www.thelancet.com/journals/lanonc/article/PIIS1470-2045(14)71183-0/abstract?elsca1=etoc&elsca2=email&elsca3=1470-2045_201501_16_1_&elsca4=Surgical%20Oncology%7CInternal%2FFamily%20Medicine%7CRadiation%20Oncology%7COncology%7CLancet








